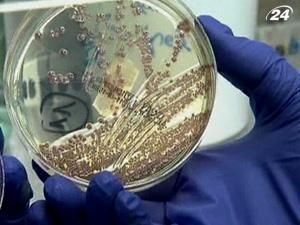
Підсумок тижня: Європою поширюється кишкова інфекція Підсумок тижня: Європою поширюється кишкова інфекція

Ще дві тисячі осіб заразилися. Недуга проникла у десяток європейських країн, зокрема випадки інфекції зафіксовані в Данії, Нідерландах, Іспанії, Великій Британії. Є випадки захворювання і в США.
Більшість заражених - іспанці та німці, або ті хто подорожував Німеччиною. За даними Всесвітньої організації охорони здоров'я, захворювання викликане невідомим раніше високотоксичним різновидом бактерії Escherichia coli. Більшість антибіотиків на неї не діють.
Інфекція передусім вражає кров і нирки, спричиняючи гостру ниркову недостатність. Глава Інституту Роберта Коха, який стежить за розвитком епідемії в Німеччині, заявив, що хвороба може тривати протягом декількох місяців.
“Ми визначили що це новий штам, якого ми не бачили раніше. Свої висновки ми представимо пізніше”, - каже бактеріолог Хольгер Роде.
“Ми з’ясували, що жінки легше заражаються, ніж чоловіки. В групі ризику - молоді жінки, а також вагітні”, - каже науковець Йорг Дебатін.
Фахівцям важко було встановити джерело інфекції. Припускали, що недуга поширюється через харчові продукти, зокрема овочі. Експерти радять добре їх мити, а ще краще піддавати термічній обробці. А у Німеччині взагалі рекомендують не їсти салат, помідори та огірки. Спалах інфекції викликав паніку серед європейців. Вони з острогою ставляться до овочів, а дехто взагалі відмовляється їх вживати.
“Так, я дуже стурбована. Я більше не їм сирих овочів, але все ще споживаю ті продукти, які пройшли термічну обробку. Крім того, я буду уважніша, купуючи овочі”, - каже покупець.
“Покупці нічого не кажуть, але вони зовсім не купують огірків. Зараз якраз сам сезон, але ми взагалі нічого не можемо продати”, - каже власник овочевої крамниці.
Спершу німецька влада, де і зафіксували найбільше недужих, повідомила, що джерелом інфекції стали огірки, завезені з Іспанії. Однак, коли провели ретельніші дослідження, з’ясувалося - в іспанських огірках дійсно виявлено хвороботворні бактерії, але вони не співпадають з бактеріями, що зумовили спалах інфекції.
Тож німці спростували свої перші висновки. Але вже було пізно. Продажі огірків в Європі різко впали. Економіка Іспанії, яку називають городом Європи, щодня втрачає сотні мільйонів євро. Іспанська влада обурена такими легковажними заявами з Німеччини, збирається притягнути Берлін до відповідальності у суді.
“Ми діяли так, як і мали діяти, і вимагаємо відшкодувань та повернути іспанські продукти на те місце, на якому вони і повинні бути. Будь-які інші дії або ж спроби політизувати цю величезну помилку німецької влади - дуже несправедливі", - каже прем’єр-міністр Іспанії Хосе Сапатеро.
“Ми вимагаємо відповідальності від Німеччини за цю несправедливу шкоду, якої неправомірно було заподіяно нашим господарствам. Ми зробимо все, аби іспанський ринок отримав відповідну компенсацію. А шкоди завдано значної”, - каже міністр сільського господарства Іспанії Роса Аґілар.
Підлила масла у вогонь і Росія. Москва, довго не розмірковуючи, заборонила імпорт овочів з країн Євросоюзу взагалі. Це викликало обурення у Брюсселі. Єврочиновники закликали Росію зняти заборону і пояснити свої крики. Налякалися заражених огірків і українські чиновники.
Прем’єр Микола Азаров запевнив, що Україна посилила контроль щодо ввезення овочів з країн ЄС. Зокрема продукти ретельніше перевіряють на кордоні. Очільник уряду зазначив, що додаткових заходів вжили одразу після випадків отруєння овочами в Європі.